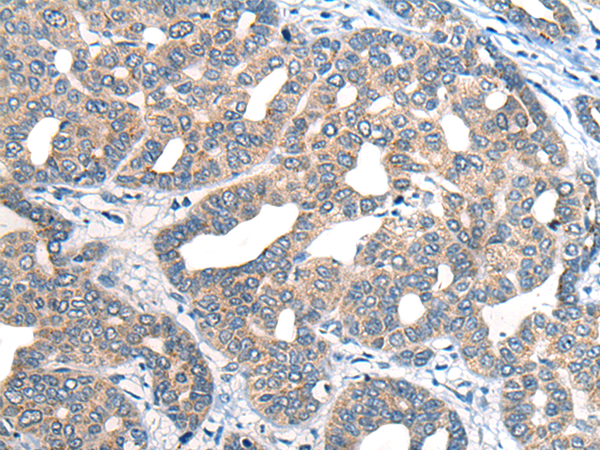
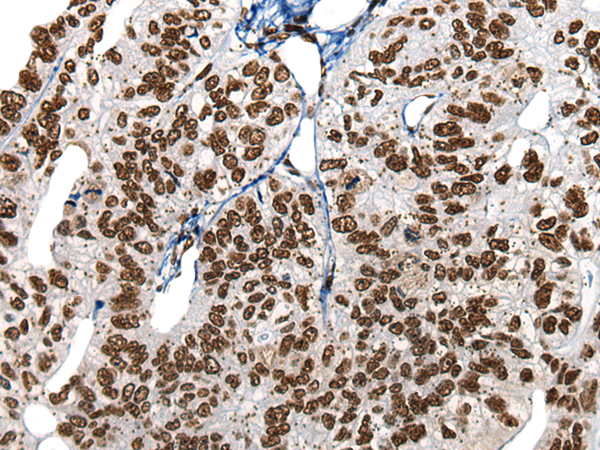
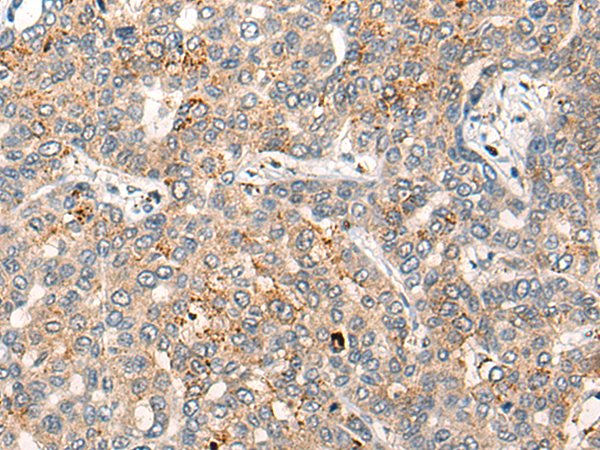

-
分类: 科研抗体货号: P13129别名: AMID; PRG3应用: IHC反应种属: Human, Mouse
-
分类: 科研抗体货号: P13149别名: HB1; HB2; HH1; IVF; VF1; HBBD; ICCD; LQT3; SSS1; CDCD2; CMD1E; CMPD2; PFHB1; Nav1.5应用: IHC反应种属: Human, Mouse, Rat
-
分类: 科研抗体货号: P13159别名: HNRPR; hnRNP-R应用: IHC反应种属: Human
-
分类: 科研抗体货号: P13146别名: SCP; SPC; UCNIII应用: WB,IHC反应种属: Human
-
分类: 科研抗体货号: P13157别名: emb; CRM1; exp1应用: WB,IHC反应种属: Human, Mouse, Rat
-
分类: 科研抗体货号: P13145别名: CKLFSF4应用: IHC反应种属: Human, Mouse
-
分类: 科研抗体货号: P13156别名: SCCD; TERE1应用: IHC反应种属: Human, Mouse, Rat
-
分类: 科研抗体货号: P13144别名: PHS; ACLS; GCPS; PAPA; PAPB; PAP-A; PAPA1; PPDIV; GLI3FL; GLI3-190应用: IHC反应种属: Human, Mouse
-
分类: 科研抗体货号: P13155别名: V8; LCDD; EWI-3应用: IHC反应种属: Human, Mouse
-
分类: 科研抗体货号: P13173别名: PRO0593应用: WB,IHC反应种属: Human, Mouse

鄂公网安备42018502007531号
鄂公网安备42018502007531号

